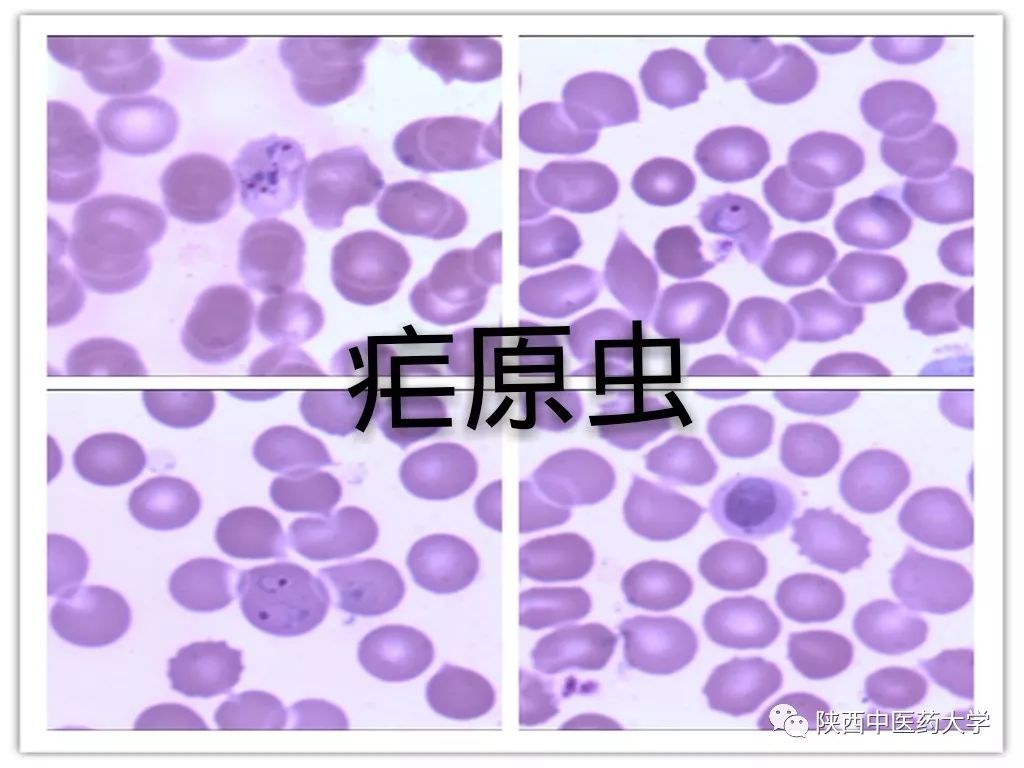
毒液的视角看毒液,医学生眼中的饮料图片

俗话说的好
外行看热闹,内行看门道
我们医学生针对《毒液》
一定要有自己的理解。
今天小编就要用些
不怎么正经风格
但专业的医学知识
介绍一下“毒液”
并安利一些电影
以引发我们医学生
针对这种现象的思考和认识。
“毒液” 是一种有思想的外星有机生命共生体,几乎以液体状的情势出现。它需要与一个宿主结合才能生存,并能赋予宿主强大的力量和能力。当毒液共生体与宿主结合时,这两种生命情势的生命体才能被称作毒液,如果宿主是好人,可以让好人越战越勇,成为超级英雄,如果结合的是坏人,会使其变成超级反派。

其实我们仔细想想
这不是“寄生”吗?
所谓寄生,
就是一种生物得靠另一种生物活着。
总的来说寄生的类型可以分成四大类
依赖型 懒汉型 *脑洗**型 杀手型

依赖型
一种生物想要活着,就只能寄生在另一种生物体内。不能独自成活,吃人家的,喝人家的。在生物学上,这一类叫专性寄生。人体里常见的寄生虫,基本上都属于这一类,比如蛔虫、钩虫等等……

依赖型的寄生虫
天生都有带钩的吸盘
一旦找到包吃包住的宿主
就不断地生孩子
不遗余力地开枝散叶 壮大种族
比如《天外魔花》里的外星生物就是这种类型
他们的最高追求就是寄生和繁殖
这种关于依赖型寄生虫的题材拍过四版电影
《天外魔花》、《人体异形》
《异形基地》、《致命拜访》

懒汉型
电影《恐怖废墟》里虚构了一种杀人藤。

乍看一下
和普通植物没什么区别
当地人都不敢招惹它们,
因为它们可以自由生长,
也能寄生在
送上门的活物身上
明明靠自己也能活
偏要赖在人家身上好吃懒做
我们把它叫做懒汉型
学名称之为兼性寄生物。
粪类圆线虫是典型的
懒汉型寄生虫

正常情况下
土生土长也没问题
可是千万不能给它机会
一上身麻烦就大了
这样的生物无论是在电影中
还是在现实中
都十分的危险!

*脑洗**型
韩国拍了一部《铁线虫入侵》,看上去十分的恐怖。

然而,实际上铁线虫寄生人体的概率很低。不过铁线虫有一点特别恐怖,它们能控住宿主跳水自杀。吃人家的喝人家的,还把人家弄傻、 弄呆、 弄成自己的傀儡。这一类寄生物 ,我们称它是*脑洗**型寄生,比如热带雨林有一种僵尸真菌,最喜欢“麻醉”路过的蚂蚁,把它们变成提线木偶,爬到温度合适的地方,再靠蚂蚁生长、 成熟、 继续传播。彩釉吸虫也会这门手艺,把蜗牛弄傻以后,操纵它们爬到最显眼的地方吸引鸟类捕食,然后它们在进入鸟类体内继续寄生。这种*脑洗**寄生的套路也被大量用在电影里:《隐藏杀手》、《傀儡主人》、《老师不是人》、《太空异种》、《撕裂人》、《宿主》。

都是这个模式
人一旦被附体
就开始了真正的傀儡人生
虽然目前人类身上
还没有发现过如此寄生虫病
但环境在日新月异的变幻着
物种之间的更新交替
人类总会感染上新的病种
作为医学生的我们
一定要有针对疾病治疗的远见
做到防患于未然。

杀手型
《异形》中的抱脸虫给不少观众留下了心理阴影。

这种设定来自赫赫有名的寄生蜂
它们靠吃人家的血肉繁衍后代
属于杀手型的寄生物
在生物学上也叫拟寄生物
拟寄生物有啥特别
比方说普通的寄生是把宿主看成“面包加工厂”
只要持续产出“面包”就行
顶多“面包师”苦点累点
拟寄生不仅会占领“工厂”
还要杀死“面包师”
本质上是一种捕食
拿寄生蜂来说
它们把卵生在花蛾的大白蛹里
等于给自己的孩子找了个蜜罐子
不愁吃不愁穿
寄生蜂的孩子“长大成人”以后
花蛾的孩子也跟着死亡了
《异形》也是用这种方式
培育后代
异形皇后负责产卵
卵里的抱脸虫寄生到人体里
异形幼虫开始生长
最后破胸而出
杀死人类
之后它们开始独立生活
电影里的寄生模式
大多都是从
自然界的真实案例来的
只不过进行了一些改动。

此上都讲解了寄生物针对宿主的危害
但寄生现象并不是全部都是有害的
总的来说寄生现象分为一下三种:
1 共栖(commensalism)
两种生物在一起生活,其中一方受益,另一方既不受益,也不受害,称为共栖。例如,鲫鱼用其背鳍演化成的吸盘吸附在大型鱼类的体表被带到各处,觅食时暂时离开,这对鲫鱼有利,对大鱼也无害。

2 互利共生(mutualism)
两种生物在一起生活,长期共生,双方有利,称为互利共生。“毒液”和他的宿主显然是这种关系,“毒液”侵入后,宿主的身体机能和思维能力得到了显著的提升,而艾迪为毒液提供了一个能够在地球生存的容器,使毒液能够活下去。

3 寄生(parasitism)
在两种生物共生的关系中,营寄生生活过程中获益,而被寄生的生物则受害。在寄生生活中过程中,营寄生生活的生物称为寄生物(parasite),被寄生的生物称为宿主(host)。

而寄生虫病在人体常见的为:
1 ·.似蚓蛔线虫
似蚓蛔线虫简称蛔虫,成虫寄生于小肠,可引起蛔虫病。成虫呈长圆柱形,外形似蚯蚓;活时略带粉红色,死后呈灰白色,两端尖细,体表光滑而有细纹。雌雄异体,雌虫较大,后端尖细而宜,雄虫后端弯曲。

2 ·.蠕形住肠线虫
蠕形住肠线虫简称蛲虫,成虫主要寄生在人体的回盲部,引起蛲虫病。儿童感染率高于成人,尤以集体生活的儿童感染率高。成虫虫体细小乳白色,似线头状;体前端角皮膨大呈头翼;咽管末端膨大呈球状,雌雄异体。患者常有烦躁不安、失眠、食欲减退、夜惊等表现,长期反复感染,会影响儿童的健康成长。

3 ·.华支睾吸虫
华支睾吸虫又叫肝吸虫。成虫寄生于人体的肝胆管内,可引起华支睾吸虫病。成虫体形狭长,前端稍窄,后端钝圆,背腹扁平,形似葵花子。

4 ·.疟原虫
寄生于人体的疟原虫有四种,即间日疟原虫、恶性疟原虫、三日疟原虫和卵形疟原虫,分别引起间日症、恶性症、三日症和卵形症。
那么,作为医学生的我们能否找到用中药治疗寄生虫的方法呢?
2015年,我国科学家屠呦呦发现用*醚乙**提取青蒿素能有效治疗疟疾的事件轰动世界,而青蒿素治疗疟疾的例子首次出现在东汉葛洪所著《肘后急备方》,此书为我国杰出的古代中医药文献。从那以后,人们终于对中药“刮目相看”。
还有很多高效治疗寄生虫的中药,请往下看:

使君子:味甘,性温,杀虫消积,主要治疗蛔虫、蛲虫、小儿疳积等

苦楝皮:味苦,性寒,杀虫疗癣,主要治疗蛔虫、蛲虫、钩虫等

槟榔:味苦辛涩,性温,杀虫消积,行气,利水,截疟。主要治疗绦虫、姜片虫、蛔虫、钩虫、蛲虫等

南瓜子:味甘,性平,杀虫,用治绦虫症、对血吸虫、蛔虫、蛲虫也有治疗功效

鹤草芽:味苦涩,性凉,主要治疗绦虫症

雷丸:味微苦,性寒,用于治疗绦虫、蛔虫、钩虫等症,且以驱杀绦虫为佳

鹤虱:味苦辛,性平,杀虫消积,主要治疗蛔虫、蛲虫、钩虫及绦虫等症

榧子:味甘,性平,杀虫消积,主要治疗虫积腹痛、小儿疳积

芜荑:味苦辛,性温,杀虫,主要治疗绦虫、蛲虫引起的病症

川楝子:味苦,性寒,疏肝泄热,行气止痛,杀虫

寄生虫病虽小,却能对人体引起极大危害;预防寄生虫病的工作,要从平时做起,从细微之处做起,从吃穿住行做起。染上寄生虫病也莫慌,中药治疗,治根治本,让你脱离寄生虫危害。
小编也希望有一天能“感染”上“毒液”,成为拯救世界的超级英雄,而我们针对病理的研究也是在拯救世界。
亲爱的同学们,你们说对吗?

文案编辑:王雨辰、周杰
网络主播:菘蓝(李锦慧)
网络编辑:褚宇鹏
素材来源:官微素材库、网络
11月23日陕中电影,点击“阅读原文”订票